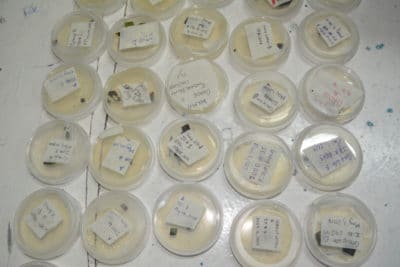
JAMIN Disease 2017

Sometimes no matter how much we try to schedule activities during our Mangrove Education and Restoration Programs, there are unforeseen events that arise at the schools. That is exactly what occurred during phase 2 of the J.A.M.I.N. program. Due to scheduling conflicts, we had to postpone our mangrove disease activities in Jamaica until this third phase.
During phase 2, through a new partnership with North Carolina State University, we provided students in our year 2 B.A.M. program with an opportunity to be at the forefront of current mangrove research. Our students worked alongside Ryann Rossi, a PhD Candidate from North Carolina State University, who is studying mangrove disease in the Bahamas. The students learned how to identify and collect potentially diseased mangrove leaves and then placed them on an agar plate to grow. After waiting for about 2-3 weeks, students learned how to identify the fungus. They found similar results to what Ryann has been finding in Abaco, the Bahamas.
Students at Forest Heights Academy smile proudly displaying their plated mangrove leaves.
 Before plating their disease leaves, students at Forest Heights Academy sterilize their lab equipment to avoid contamination.
Before plating their disease leaves, students at Forest Heights Academy sterilize their lab equipment to avoid contamination.
B.A.M. participant works with North Carolina University PhD Candidate, Ryann Rossi, to plate their diseased mangroves leaves.
Now it’s time for the J.A.M.I.N. students to figure out whether or not they would find the same fungus that is suspect of causing mangrove disease in the Bahamas. Never before have scientists looked for fungal disease on mangrove leaves in Jamaica. Students in the year 2 J.A.M.I.N. program will be the first to pioneer this important scientific work.
Students at William Knibb High School plate their mangrove leaves in agar to find out which fungus might be present in the mangroves in Jamaica.
The agar plates sent to Ryann Rossi at North Carolina University.
Stay tuned to find out the students’ results!